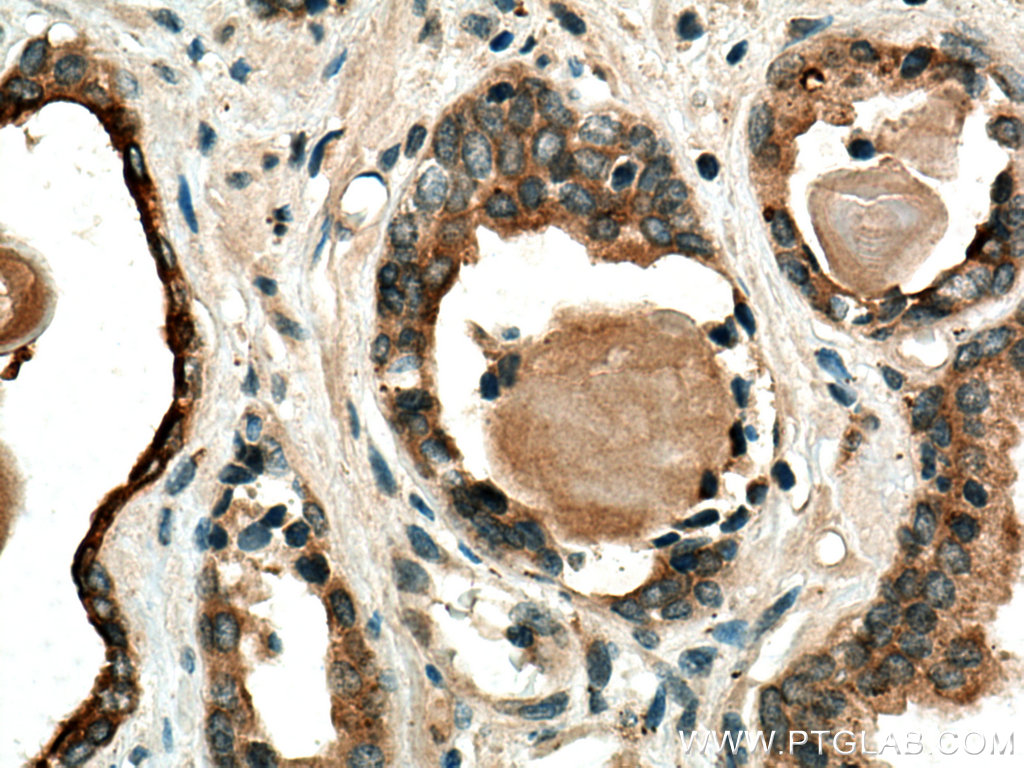

验证数据展示
经过测试的应用
| Positive WB detected in | A549 cells, human placenta tissue, SKOV-3 cells, NIH/3T3 cells, COLO 320 cells, PC-3 cells |
| Positive IHC detected in | human pancreas cancer tissue, human prostate cancer tissue, human colon cancer tissue, human stomach cancer tissue Note: suggested antigen retrieval with TE buffer pH 9.0; (*) Alternatively, antigen retrieval may be performed with citrate buffer pH 6.0 |
| Positive IF-P detected in | human pancreas cancer tissue |
推荐稀释比
| 应用 | 推荐稀释比 |
|---|---|
| Western Blot (WB) | WB : 1:1000-1:4000 |
| Immunohistochemistry (IHC) | IHC : 1:50-1:500 |
| Immunofluorescence (IF)-P | IF-P : 1:50-1:500 |
| It is recommended that this reagent should be titrated in each testing system to obtain optimal results. | |
| Sample-dependent, Check data in validation data gallery. | |
产品信息
10374-2-AP targets MMP7 in WB, IHC, IF-P, ELISA applications and shows reactivity with human, mouse samples.
| 经测试应用 | WB, IHC, IF-P, ELISA Application Description |
| 文献引用应用 | WB, IHC, IF |
| 经测试反应性 | human, mouse |
| 文献引用反应性 | human, mouse, rat, pig |
| 免疫原 |
CatNo: Ag0550 Product name: Recombinant human MMP7 protein Source: e coli.-derived, PGEX-4T Tag: GST Domain: 1-100 aa of BC003635 Sequence: MRLTVLCAVCLLPGSLALPLPQEAGGMSELQWEQAQDYLKRFYLYDSETKNANSLEAKLKEMQKFFGLPITGMLNSHVIEIMQKPRCGVPDVAEYSLFPN 种属同源性预测 |
| 宿主/亚型 | Rabbit / IgG |
| 抗体类别 | Polyclonal |
| 产品类型 | Antibody |
| 全称 | matrix metallopeptidase 7 (matrilysin, uterine) |
| 别名 | EC:3.4.24.23, Matrilysin, Matrin, Matrix metalloproteinase 7, Matrix metalloproteinase-7 |
| 计算分子量 | 29 kDa |
| 观测分子量 | 28-30 kDa |
| GenBank蛋白编号 | BC003635 |
| 基因名称 | MMP7 |
| Gene ID (NCBI) | 4316 |
| RRID | AB_2144452 |
| 偶联类型 | Unconjugated |
| 形式 | Liquid |
| 纯化方式 | Antigen affinity purification |
| UNIPROT ID | P09237 |
| 储存缓冲液 | PBS with 0.02% sodium azide and 50% glycerol, pH 7.3. |
| 储存条件 | Store at -20°C. Stable for one year after shipment. Aliquoting is unnecessary for -20oC storage. |
背景介绍
Matrix metalloproteinase-7 (MMP-7)/ matrilysin is a member of the MMP family, but is structurally different from the other MMPs by virtue of the absence of a conserved COOH-terminal protein domain. MMPs are involved in the breakdown of extracellular matrix in normal physiological processes, such as embryonic development reproduction, and tissue remodeling, as well as in disease processes, such as arthritis and cancer metastasis. Most MMP's are secreted as inactive proproteins which are activated when cleaved by extracellular proteinases. MMP-7 degrades proteoglycans, fibronectin, elastin and casein, and is involved in wound healing, tumor progression, pulmonary fibrosis, and development of choroidal neovascularization in age-related macular degeneration. The expression of MMP-7 is increased in most tumors. This antibody can only recognize the full-length of MMP7.
实验方案
| Product Specific Protocols | |
|---|---|
| IF protocol for MMP7 antibody 10374-2-AP | Download protocol |
| IHC protocol for MMP7 antibody 10374-2-AP | Download protocol |
| WB protocol for MMP7 antibody 10374-2-AP | Download protocol |
| Standard Protocols | |
|---|---|
| Click here to view our Standard Protocols |
发表文章
| Species | Application | Title |
|---|---|---|
Nat Aging Single-cell and spatial RNA sequencing identify divergent microenvironments and progression signatures in early- versus late-onset prostate cancer | ||
Cancer Res Hypoxic tumor-derived exosomal miR-301a mediates M2 macrophage polarization via PTEN/PI3Kγ to promote pancreatic cancer metastasis. | ||
Cancer Res Ubiquitin-like protein FAT10 promotes the invasion and metastasis of hepatocellular carcinoma by modifying β-catenin degradation. | ||
Oncogene Transducin (β)-like 1 X-linked receptor 1 promotes gastric cancer progression via the ERK1/2 pathway. | ||
Clin Cancer Res BATF2 Deficiency Promotes Progression in Human Colorectal Cancer via Activation of HGF/MET Signaling: A Potential Rationale for Combining MET Inhibitors with IFNs. |